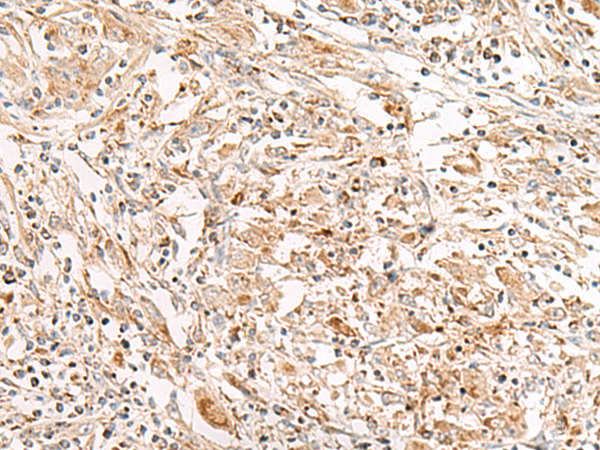

|
Background: |
This gene, a member of the histidine triad gene family, encodes a diadenosine 5',5'''-P1,P3-triphosphate hydrolase involved in purine metabolism. The gene encompasses the common fragile site FRA3B on chromosome 3, where carcinogen-induced damage can lead to translocations and aberrant transcripts of this gene. In fact, aberrant transcripts from this gene have been found in about half of all esophageal, stomach, and colon carcinomas. Alternatively spliced transcript variants have been found for this gene. |
|
Applications: |
ELISA, WB, IHC |
|
Name of antibody: |
FHIT |
|
Immunogen: |
Fusion protein of human FHIT |
|
Full name: |
fragile histidine triad |
|
Synonyms: |
FRA3B, AP3Aase |
|
SwissProt: |
P49789 |
|
ELISA Recommended dilution: |
1000-5000 |
|
IHC positive control: |
Human thyroid cancer |
|
IHC Recommend dilution: |
25-100 |
|
WB Predicted band size: |
17 kDa |
|
WB Positive control: |
Human fetal kidney tissue |
|
WB Recommended dilution: |
200-1000 |
購(gòu)物車
購(gòu)物車 幫助
幫助
 021-54845833/15800441009
021-54845833/15800441009
